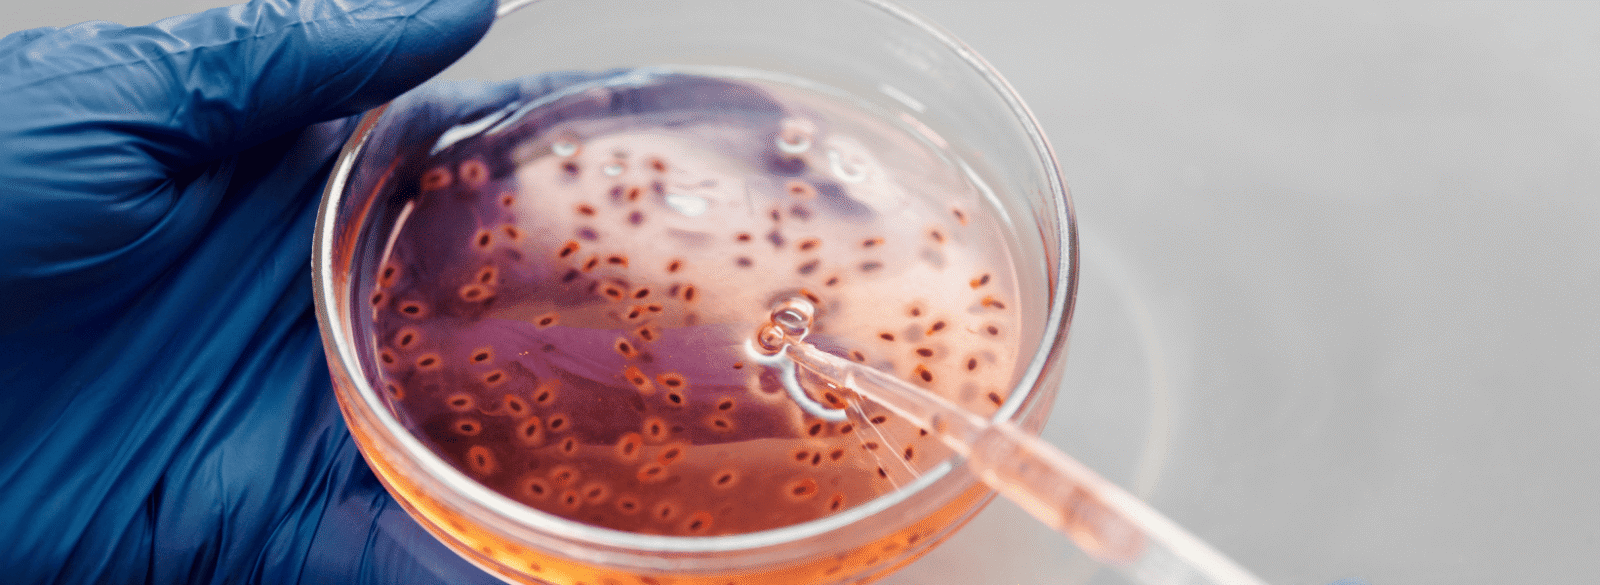

Proekspert developed BioXpert XP for Applikon Biotechnology, enabling precise control of fermentation processes, secure data handling, and improved bioreactor management.
Applikon Biotechnology B.V. develops bioreactors used in research and industrial biotechnology, where fermentation processes must be precisely controlled and continuously monitored.
These processes depend on careful management of variables such as temperature, pH, oxygen levels, agitation, and nutrient supply.
Applikon needed a reliable software platform that could bring process control, monitoring, and data management into a single system, giving researchers better visibility into fermentation processes and supporting increasingly complex biotechnology experiments.
Proekspert partnered with Applikon Biotechnology to develop BioXpert XP, a comprehensive SCADA software platform designed specifically for bioreactor control and fermentation process management.
From the beginning, the goal was to deliver a dependable production system capable of meeting strict safety, usability, and data management requirements common in biotechnology environments.
Our team combined software engineering expertise with biotechnology domain knowledge to design a system that enables precise process control and reliable monitoring of fermentation processes.
Key responsibilities and deliverables:
The result was BioXpert XP, a user-friendly software platform that combines process control, monitoring, and data analysis into a single integrated solution.
Bottom line: Proekspert delivered a mission-critical software system that allows researchers and operators to monitor, control, and analyze fermentation processes from one unified platform.
With BioXpert XP in place, Applikon’s bioreactor systems gained a powerful software platform that improves both operational control and data visibility.
Researchers and operators can now monitor fermentation processes in real time, collect detailed experimental data, and analyze results more effectively. The integrated software environment simplifies the management of complex experiments and supports more reliable scientific outcomes.
The platform also ensures consistent data handling and secure process monitoring, enabling laboratories and research facilities to maintain high standards of experimental accuracy and traceability.
The project also positioned Proekspert as a pioneering developer of software solutions for bioreactor control.
These capabilities translate directly into business value for Applikon:
“We chose Proekspert because of the company’s strong know-how. They are fully up-to-date with the newest platforms, and the development process of BioXpert XP exhibited excellent co-development between our two companies.”
Arthur Oudshoorn
Managing Director, Applikon Biotechnology B.V.
Applikon Biotechnology B.V. was a manufacturer of bioreactor systems used in biotechnology research and industrial fermentation. Founded in 1973, the company grew from a small laboratory instrumentation supplier into an international provider of advanced bioprocess equipment. In 2020, Applikon became part of the Getinge Group. The company’s bioreactor solutions help researchers and biotechnology companies control, monitor, and optimize complex biological processes.
SCADA software, Microsoft technologies, DCOM communication, Microsoft SQL Server / MSDE databases.
Our case studies give an insight into how human-oriented design principles will help product companies persuade customers to go on a journey with smart, connected products.
Your message has been sent. Our team will get back to you as soon as possible!